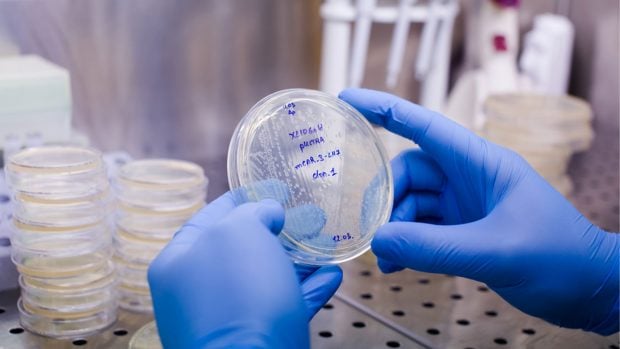
Terapia CAR-T

Terapias con exosomas: la nueva frontera en antienvejecimiento y reparación celular
Las terapias con exosomas representan una auténtica nueva frontera en antienvejecimiento y reparación celular.
Dieta antienvejecimiento
¿Adiós al envejecimiento?
Consejos de alimentación antienvejecimiento

En la búsqueda constante por envejecer mejor y mantener el cuerpo funcionando de forma óptima, la ciencia ha ido afinando la mirada hasta niveles casi microscópicos. Y es ahí, en ese mundo diminuto pero decisivo, donde aparecen los exosomas. Aunque su nombre pueda sonar técnico o lejano, hoy se habla de ellos como uno de los avances más interesantes en antienvejecimiento y reparación celular. No prometen milagros inmediatos, pero sí una forma más inteligente de ayudar al organismo a recuperarse y mantenerse sano.
¿Qué son los exosomas y por qué son tan importantes?
Los exosomas son pequeñas vesículas que las células liberan de manera natural para comunicarse entre sí. Son extremadamente pequeños, invisibles incluso con microscopios convencionales, pero transportan información valiosísima: proteínas, lípidos y fragmentos de ARN que influyen directamente en el comportamiento de otras células.
Durante mucho tiempo pasaron desapercibidos o se consideraron simples residuos celulares. Hoy se sabe que cumplen un papel esencial en procesos como la regeneración de tejidos, la respuesta inmunitaria y el equilibrio interno del organismo. En cierto modo, son como mensajes cuidadosamente empaquetados que las células se envían para coordinarse.
Esta función comunicadora es lo que los convierte en una herramienta tan atractiva desde el punto de vista terapéutico.
Exosomas y envejecimiento celular
El envejecimiento no es solo una cuestión de arrugas o canas; ocurre a nivel celular. Con los años las células pierden eficiencia, se comunican peor entre sí y responden con menos rapidez al daño o al estrés.
Aquí es donde los exosomas despiertan tanto interés. Los exosomas obtenidos de células jóvenes o de células madre contienen señales capaces de “reactivar” ciertos procesos celulares. Entre los efectos más estudiados se encuentran:
Disminución de la inflamación persistente
- Estimulación de colágeno y elastina
- Mejora del metabolismo celular
- Activación de mecanismos naturales de reparación
- Más que rejuvenecer de golpe, ayudan a que las células funcionen de forma más parecida a como lo hacían antes, algo clave para un envejecimiento más saludable.
Terapias con exosomas: cómo funcionan
A diferencia de las terapias celulares clásicas, las terapias con exosomas no introducen células nuevas en el cuerpo. En su lugar, aprovechan los mensajes que esas células producen de forma natural.
En la práctica clínica, los exosomas se obtienen a partir de cultivos celulares en laboratorio, se aíslan cuidadosamente y se concentran. Después, se aplican según el objetivo terapéutico mediante:
- Inyecciones localizadas
- Aplicaciones tópicas, sobre todo en tratamientos cutáneos
- Combinación con procedimientos médicos o estéticos
Una vez en el tejido, los exosomas interactúan con las células existentes y estimulan procesos de reparación sin alterar la estructura natural del tejido.
Aplicaciones en antienvejecimiento
El campo donde más rápidamente se han adoptado estas terapias es el del antienvejecimiento, especialmente en la piel. Esto se debe a que la piel refleja muy bien los cambios celulares.
Algunas de sus aplicaciones más habituales incluyen:
- Mejora visible de la calidad y textura de la piel
- Aumento de la elasticidad y luminosidad
- Apoyo en la recuperación tras tratamientos estéticos
- Mejora del aspecto de cicatrices y piel dañada por el sol
A diferencia de otros procedimientos, los exosomas no “rellenan” ni bloquean movimientos. Trabajan de forma progresiva, estimulando a la piel para que se regenere por sí misma, lo que suele traducirse en resultados más naturales.
Reparación celular y medicina regenerativa
Más allá de la estética, los exosomas están despertando un enorme interés en la medicina regenerativa. Su capacidad para modular la inflamación y favorecer la reparación de tejidos los hace especialmente útiles en:
- Lesiones musculares
- Problemas articulares
- Recuperación de tendones y ligamentos
- Procesos inflamatorios persistentes
En áreas más complejas, como el sistema nervioso, todavía se encuentran en fases experimentales, pero los resultados preliminares son prometedores. Una de sus grandes ventajas es que no se multiplican ni se transforman, lo que reduce ciertos riesgos asociados a otras terapias avanzadas.
Ventajas frente a otras terapias avanzadas
El interés creciente por las terapias con exosomas se debe, en gran parte, a sus beneficios comparativos:
- Alta compatibilidad con el organismo
- Bajo riesgo de rechazo inmunológico
- No contienen células vivas completas
- Actúan respetando los procesos naturales del cuerpo
- Pueden combinarse con otros tratamientos
- Todo esto hace que se perciban como una opción más equilibrada entre eficacia y seguridad.
Limitaciones y estado actual de la ciencia
A pesar del entusiasmo, conviene mantener los pies en la tierra. Las terapias con exosomas aún están evolucionando y presentan ciertos límites:
- No todas las aplicaciones están completamente validadas
- La calidad de los productos puede variar mucho
- Los protocolos todavía se están estandarizando
La investigación continúa avanzando para definir mejor dosis, indicaciones y métodos de aplicación. Por eso, es fundamental recurrir siempre a profesionales cualificados y centros con experiencia contrastada.
Aunque aún queda camino por recorrer en investigación y regulación, todo apunta a que los exosomas tendrán un papel cada vez más relevante en la medicina del futuro. No prometen detener el paso del tiempo, pero sí acompañarlo de una forma más saludable y consciente.
Lecturas recomendadas
Temas:
- Envejecimiento